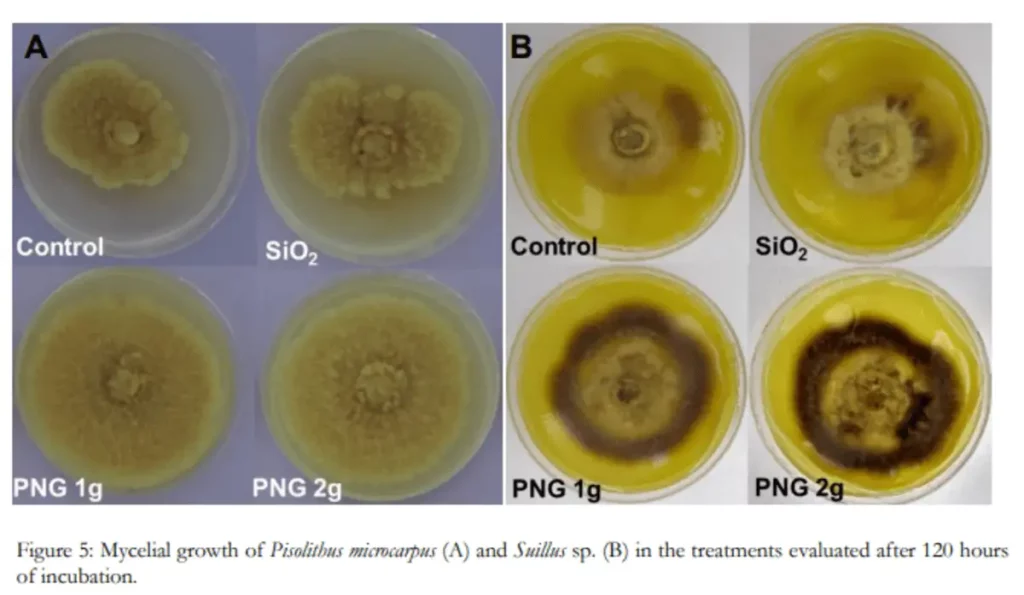
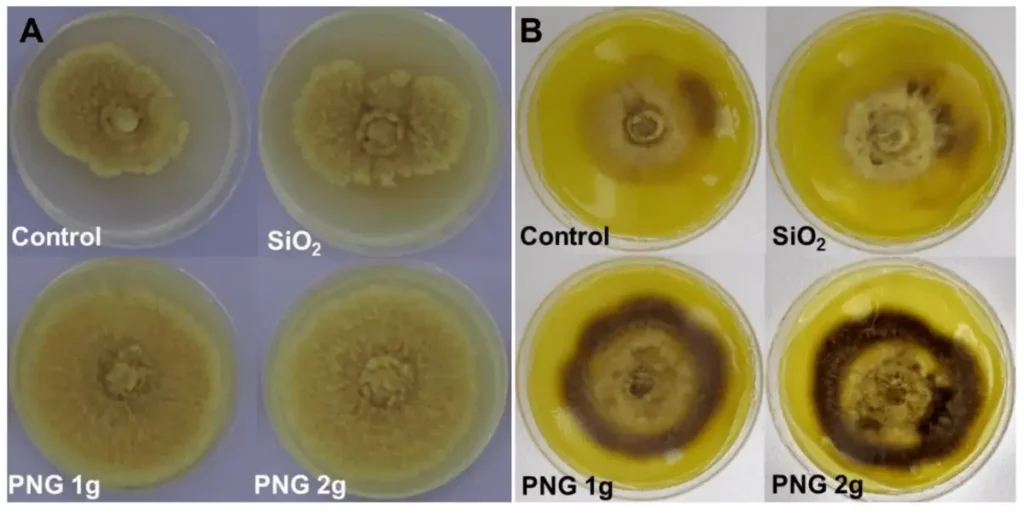

Penergetic B & P
Lorem ipsum dolor sit amet, consectetur adipiscing elit. Ut elit tellus, luctus nec ullamcorper mattis, pulvinar dapibus
Fachberater
Ricardo Bemfica Steffen and Gerusa Pauli Kist Steffen PhD in Soil Science BRAZIL
Anwender
Wissenschaftlicher Versuch mit Netzbeuteln
Mycelial growth of Pisolithus microcarpus (A) and Suillus sp. (B) in the treatments evaluated after 120 hours of incubation with penergetic (PNG1 and PNG 2) and without penergetic (Control and SiO2)
Wissenschaftliche Veröffentlichung: In-vitro-Aktivierung von mikrobiellem Wachstum in niederfrequenten elektromagnetischen Feldern
„Bei der Verwendung des kommerziellen Biostimulators in Kulturmedium wurden signifikante Zunahmen des Pilz- und Bakterienwachstums beobachtet.“
Veröffentlichung von Ricardo Bemfica Steffen, Gerusa Pauli Kist Steffen & Joseila Maldaner im Journal of Agriculture and Environmental Sciences, Juni 2020, Vol. 9, Nr. 1, S. 1-7
Zusammenfassung
Die in der Landwirtschaft weltweit zu beobachtenden Produktivitäts- und Qualitätssteigerungen führen zum Einsatz neuer Technologien, die den aktuellen Anforderungen gerecht werden. Der Einsatz von niederfrequenten elektromagnetischen Feldern hat bedeutende Ergebnisse gezeigt. In diesem Zusammenhang war das Ziel dieser Studie, die Auswirkungen der Penergetic-Technologie auf die direkte Stimulierung von nützlichen Bodenmikroorganismen unter in vitro Bedingungen zu bestimmen. Es wurden das Myzelwachstum und die Konidienbildung von Trichoderma asperelloides, das Myzelwachstum der Ektomykorrhizapilze Pisolithus microcarpus und Suillus sp. sowie die Vermehrung von Bakterienzellen der Spezies Bradyrhizobium japonicum in Kulturmedium mit und ohne Zusatz von Penergetic untersucht. Bei der Verwendung des Biostimulators im Nährmedium wurden signifikante Steigerungen des Pilz- und Bakterienwachstums beobachtet. Der Einsatz nachhaltiger technologischer Hilfsmittel stellt einen gangbaren Weg dar, da es sich um eine solide und effiziente Bewirtschaftungsalternative handelt, die in der Lage ist, den Anreiz für die biologische Entwicklung im Boden und folglich die landwirtschaftliche Produktivität auf umweltfreundliche und nachhaltige Weise zu erhöhen.
Autoren der Studie: Ricardo Bemfica Steffen, Gerusa Pauli Kist Steffen & Joseila Maldaner
Methode
Die direkte Wirkung der Technologie wurde auf zwei Pilzgruppen und eine Bakteriengruppe untersucht, die alle natürlich im Boden vorkommen und weltweit verbreitet sind. Für diese Studie wurden der Pilz Trichoderma asperelloides (biologischer Schädlingsbekämpfer und Pflanzenwachstumsförderer), zwei Arten von Ektomykorrhizapilzen Pisolithus microcarpus und Suillus sp. (symbiotische Pilze von Waldarten) und das Bakterium Bradyrhizobium japonicum (biologische stickstofffixierende Bakterien) verwendet.
Es wurden vier Behandlungen bewertet:
- Control Kontrollbehandlung (mit unveränderten Nährmedien)
- SiO2 Siliziumdioxid-Behandlung (Zugabe von handelsüblichem SiO2 in das Kulturmedium)
- PNG 1g und PNG 2g Zwei Dosierungen von Penergetic p (1 und 2 Gramm Penergetic pro Liter Medium)

Abbildung 1: Wachstum von Trichoderma asperelloides, bestimmt durch den Durchmesser des Sporenrandes und die Anzahl der Konidien pro Platte. *Mittelwerte, die auf denselben Buchstaben folgen, unterscheiden sich nicht durch den Tukey-Test bei einer Wahrscheinlichkeit von 5 %.
Ergebnisse und Diskussion
Die in kontrollierten Umgebungen erzielten Ergebnisse der Versuche zur Stimulierung von Mikroorganismen zeigten die zunehmende Wirkung auf T. asperelloides (Biokontrollmittel und Pflanzenwachstumsförderer), P. microcarpus und Suillus sp. (Ektomykorrhizapilze) und das Bakterium B. japonicum. Diese Ergebnisse zeigen, dass die Verwendung des Pflanzenprodukts penergetic p einen direkten Nutzen für das Wachstum und die biologische Aktivität der untersuchten Mikroorganismen hat.
Siliziumdioxid, ein von der Penergetic-Technologie verwendetes Substrat, führte ohne den industriellen Prozess nicht zu einer signifikanten Zunahme der Pilzentwicklung. Die Autoren beobachteten ein Stimulationspotenzial von SiO2 auf die biologische Aktivität. Bei Verwendung von elektromagnetisch bioprogrammiertem SiO2 (Penergetic Plant) wurde jedoch die Sporulation vorweggenommen und die Anzahl der Konidien pro Platte erhöht.
Weitere Einzelheiten finden Sie in der vollständigen Studie (EN), die Sie unten herunterladen können.

Myzelwachstum und Sporulationsintensität
Abbildung 2: Myzelwachstum und Sporulationsintensität von Trichoderma asperelloides in den bewerteten Behandlungen nach 120 Stunden Inkubation.

Pilzwachstum
Abbildung 3: Pilzwachstum von Pisolithus microcarpus (A) und Suillus sp. (B), bestimmt durch den Randdurchmesser.
*Mittelwerte gefolgt von demselben Buchstaben unterscheiden sich nicht durch den Tukey-Test bei einer Wahrscheinlichkeit von 5 %.

Durchschnittlicher Hyphen-Durchmesser
Abbildung 4: Durchschnittlicher Hyphen-Durchmesser (µm) der Ektomykorrhizapilze (A) Pisolithus microcarpus und (B) Suillus sp. in den verschiedenen Behandlungen. *Mittelwerte, die auf denselben Buchstaben folgen, unterscheiden sich nicht durch den Tukey-Test bei einer Wahrscheinlichkeit von 5%.
Myzelwachstum
Abbildung 5: Myzelwachstum von Pisolithus microcarpus (A) und Suillus sp. (B) in den Behandlungen, die nach 120 Stunden der Inkubation.

Koloniebildende Einheiten - Colony Forming Units (CFU)
Abbildung 6: Koloniebildende Einheiten (CFU) von Bradyrhizobium japonicum pro Milliliter der Suspension.
*Mittelwerte, die auf denselben Buchstaben folgen, unterscheiden sich nicht durch den Tukey-Test bei einer Wahrscheinlichkeit von 5 %.

